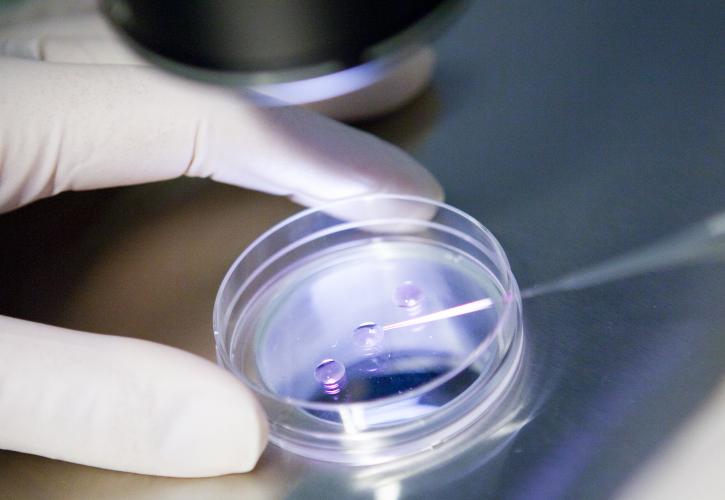
Νέα μοριακή μεθοδολογία ανίχνευσης και ανάλυσης μεταλλάξεων σε λύματα και τουριστικές δομές ανέπτυξε το ΕΚΠΑ

Nέα μοριακή μεθοδολογία ευαίσθητης ανίχνευσης και ποσοτικού προσδιορισμού των μεταλλαγμένων στελεχών/παραλλαγών του SARS-CoV-2 σε δείγματα λυμάτων με χρήση μίας σειράς μοριακών μεθόδων, στις οποίες περιλαμβάνεται και η αλληλούχηση επόμενης γενιάς (Next Generation Sequencing/NGS), έχει αναπτυχθεί στο Εθνικό και Καποδιστριακό Πανεπιστήμιο Αθηνών (ΕΚΠΑ), μέσω της συνεργασίας ερευνητικών μονάδων, στο πλαίσιο προγράμματος με επιστημονικό υπεύθυνο τον καθηγητή Ανδρέα Σκορίλα.
Το σχετικό άρθρο έχει τίτλο «Novel Nested-Seq Approach for SARS-CoV-2 Real-time Epidemiology and In-depth Mutational Profiling in Wastewater» και υπογράφεται από τους ερευνητές Μαργαρίτη Αυγέρη, Παναγιώτη Αδαμόπουλο, Αικατερίνη Γαλάνη, Μαριέτα Ξαγοράρη, Δημήτριο Γουργιώτη, Ιωάννη Τρουγκάκο, Νικόλαο Βούλγαρη, Θάνο Δημόπουλο (πρύτανης ΕΚΠΑ), Νικόλαο Θωμαΐδη και Ανδρέα Σκορίλα.
Το άρθρο έγινε δεκτό για δημοσίευση στο έγκριτο διεθνές επιστημονικό περιοδικό «International Journal of Molecular Sciences», ενώ έχει κατατεθεί από το ΕΚΠΑ αίτηση για χορήγηση Εθνικού και Διεθνούς Διπλώματος Ευρεσιτεχνίας.
Πρόκειται για μία πολύ σημαντική επιτυχία, αφού αφορά σε ανάπτυξη νέας υπερευαίσθητης μοριακής μεθοδολογίας προσδιορισμού μεταλλάξεων σε «δύσκολα δείγματα», σε διεθνές επίπεδο. Η έρευνα, κατά τη διάρκεια της αμερόληπτης αξιολόγησης, κρίθηκε από αρκετούς ανώνυμους διεθνείς κριτές, οι οποίοι αποδέχτηκαν τη μεθοδολογική διαδικασία, τη σπουδαιότητα και την πρωτοτυπία.
Η μελέτη των επιπέδων και των μεταλλαγμένων στελεχών του SARS-CoV-2 στα λύματα πόλεων και δομών αντιπροσωπεύει μία καινοτόμο και οικονομικά αποδοτική προσέγγιση δημιουργίας ενός συστήματος επιτήρησης της επιδημιολογίας του SARS-CoV-2 σε τοπικό επίπεδο πληθυσμού, αλλά και σε εθνικό επίπεδο.
Η συγκεκριμένη υπερευαίσθητη μεθοδολογία, που μπορεί να εξάγει αποτελέσματα ακόμη και σε 50ml δείγματος, είναι ιδιαίτερα σημαντική διότι δείχνει την παρουσία και την εκατοστιαία αναλογία των μεταλλαγμένων στελεχών στο σύνολο του πληθυσμού μίας πόλης ή μίας τουριστικής δομής. Η συγκεκριμένη μεθοδολογία πληροί τις προϋποθέσεις τής από 15-3-2021 σχετικής σύστασης της Ευρωπαϊκής Επιτροπής για την κοινή προσέγγιση κατά τη δημιουργία συστηματικής επιτήρησης του SARS-CoV-2 και των παραλλαγών του στα λύματα.
Επιπλέον, ανιχνεύει εγκαίρως νέες παραλλαγές που μόλις άρχισαν να εισέρχονται στον πληθυσμό. Τα πρώτα αποτελέσματα εφαρμογής της μεθόδου βρίσκονται σε συμφωνία με τα αντίστοιχα μεταγενέστερα κλινικά δεδομένα σε δείγματα ασθενών του πληθυσμού, υποστηρίζοντας την αξιοποίηση του ελέγχου των στελεχών του SARS-CoV-2 στα λύματα πόλεων ή άλλης δομής ως ένα κύριο και έγκαιρο δείκτη της εξάπλωσης νέων παραλλαγών του ιού στον πληθυσμό και κατ’ επέκταση τη λήψη στοχευμένων αποφάσεων για την αντιμετώπιση της COVID-19.
Η νέα μέθοδος καθιστά ευκολότερη τη γονιδιωματική επιτήρηση των νέων στελεχών SARS-CoV-2 και, με κατάλληλη τροποποίηση, άλλων ιών ή βακτηρίων, δίνοντας την αναγκαία πληροφόρηση για την επιδημιολογική επιτήρηση καθώς και τον ανασχεδιασμό νέων εμβολίων και φαρμακευτικών πρωτοκόλλων.
Tο pronews.gr δημοσιεύει κάθε σχόλιο το οποίο είναι σχετικό με το θέμα στο οποίο αναφέρεται το άρθρο. Ο καθένας έχει το δικαίωμα να εκφράζει ελεύθερα τις απόψεις του. Ωστόσο, αυτό δεν σημαίνει ότι υιοθετούμε τις απόψεις αυτές και διατηρούμε το δικαίωμα να μην δημοσιεύουμε συκοφαντικά ή υβριστικά σχόλια όπου τα εντοπίζουμε. Σε κάθε περίπτωση ο καθένας φέρει την ευθύνη των όσων γράφει και το pronews.gr ουδεμία νομική ή άλλα ευθύνη φέρει.
Δικαίωμα συμμετοχής στη συζήτηση έχουν μόνο όσοι έχουν επιβεβαιώσει το email τους στην υπηρεσία disqus. Εάν δεν έχετε ήδη επιβεβαιώσει το email σας, μπορείτε να ζητήσετε να σας αποσταλεί νέο email επιβεβαίωσης από το disqus.com
Όποιος χρήστης της πλατφόρμας του disqus.com ενδιαφέρεται να αναλάβει διαχείριση (moderating) των σχολίων στα άρθρα του pronews.gr σε εθελοντική βάση, μπορεί να στείλει τα στοιχεία του και στοιχεία επικοινωνίας στο info3@pronews.gr και θα εξεταστεί άμεσα η υποψηφιότητά του.